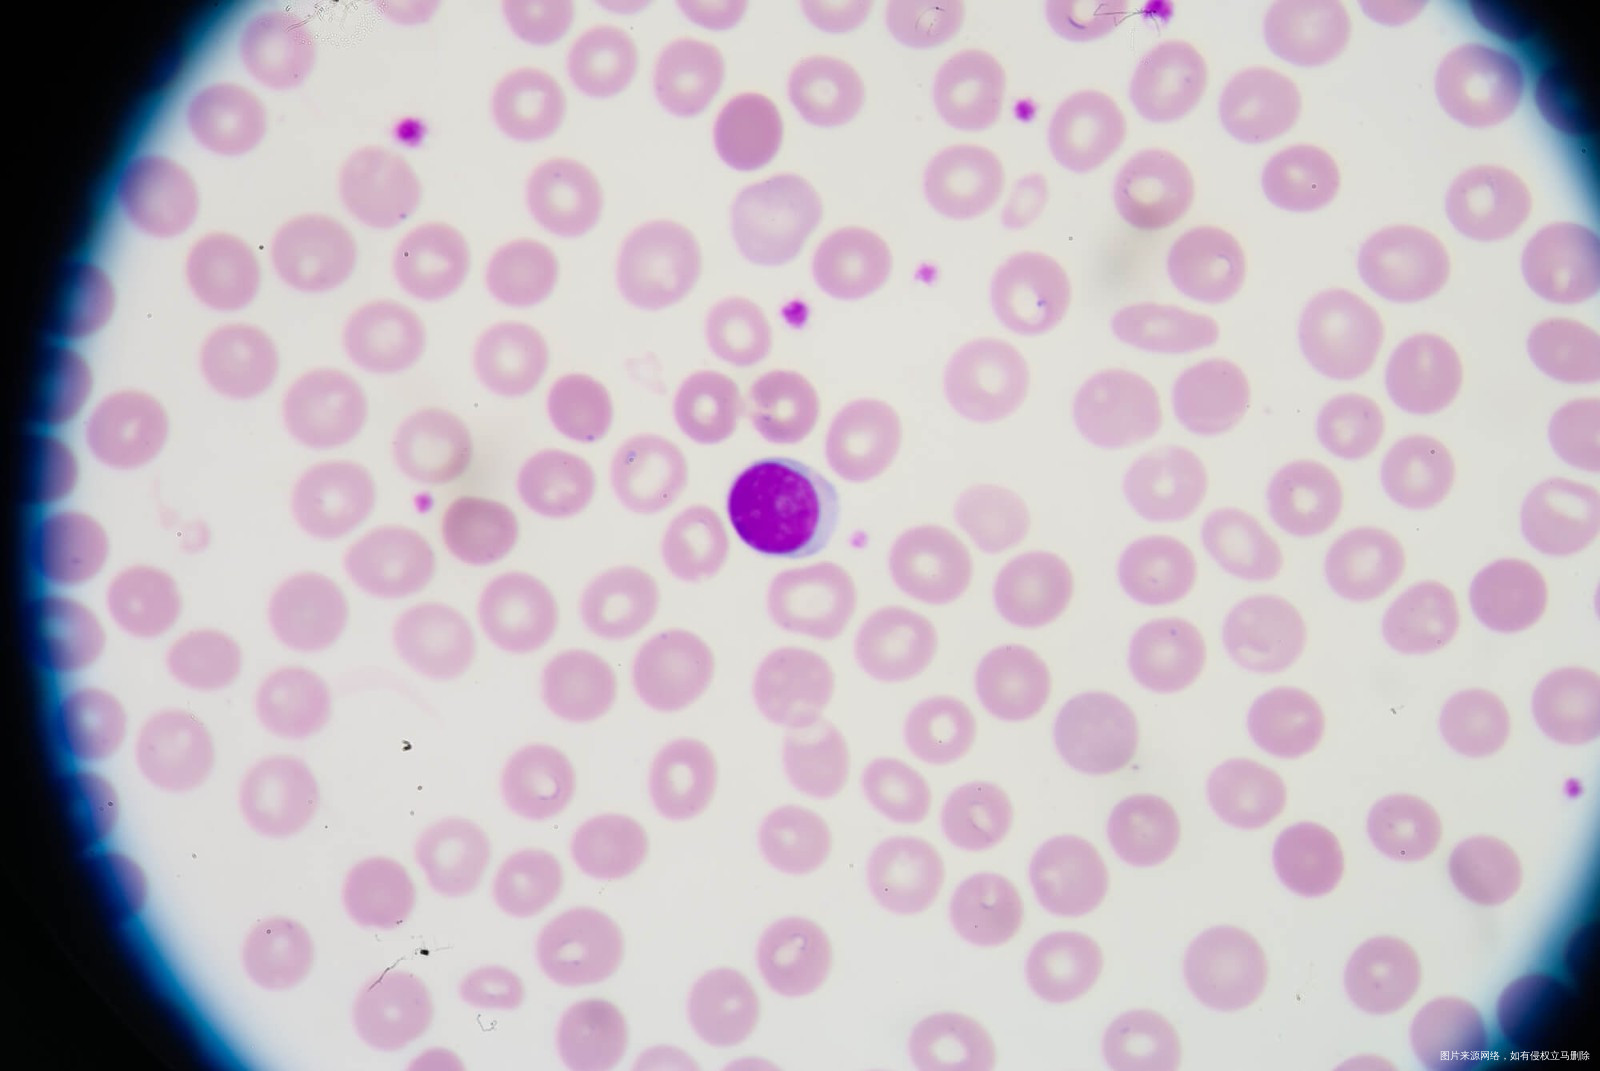

第 6 6 1 9 期
二十三岁做试管婴儿成功率高吗?一定要当心这些问题
发布:2020-03-07 19:14:12
导语
23岁这样的一个年龄如果要选择试管婴儿这项手术的话,那么肯定也都是非常不错的身体条件,因为23岁做试管婴儿相对来讲,在医学的角度来说,除非是因为自己家里面有遗传疾病
好孕百科 / 生男生女 / 二十三岁做试管婴儿成功率高吗?一定要当心这些问题
导语
23岁这样的一个年龄如果要选择试管婴儿这项手术的话,那么肯定也都是非常不错的身体条件,因为23岁做试管婴儿相对来讲,在医学的角度来说,除非是因为自己家里面有遗传疾病
二十三岁做试管婴儿成功率高吗?一定要当心这些问题
23岁这样的一个年龄如果要选择试管婴儿这项手术的话,那么肯定也都是非常不错的身体条件,因为23岁做试管婴儿相对来讲,在医学的角度来说,除非是因为自己家里面有遗传疾病,或者是说自己的身体有缺陷,要不然的话通过自然怀孕的这种方式就能够拥有自己的宝宝,医生就不会尝试患者用试管婴儿,二十三岁做试管婴儿成功率是多少?这也是很多人希望能够了解的一件事儿。
二十三岁做试管婴儿成功率是多少?
当女性是23岁的时候,如果要选择做试管婴儿这项手术的话,那么大家一定要找到根本原因,也就是说女性为什么要做试管婴儿,比如有的人可能是因为先天性的缺陷,这种情况下,如果女性体内比如说没有子宫或者是说她们的子宫畸形,那么这种情况成功的概率基本上是微乎其微,所以医生也不会建议这一部分的患者做试管婴儿,但是如果是因为一些其他原因,比如因为男性的原因,那么这种情况下试管婴儿成功率还是会非常大的。
哪些因素会影响试管婴儿成功率?
23岁的女性如果要做试管婴儿的话,想要在现在的社会中提升成功率,建议大家最好能够选择一家正规医院,因为毕竟自己的身体还年轻,所以说各方面的身体条件都非常不错,这种情况下如果大家选择的是不正规医院就会对自身产生影响,因此我们想要提升试管婴儿成功概率,就一定要考虑选择一家正规医院。这些正规医院在无形里面就会给我们带来更好的保障,所以说我们在选择医院的时候,一定要擦亮眼睛。
既然我们选择了医院,医生在最后会针对于自己的实际问题多做了解,因为医生通常来说会告诉我们为什么会出现不能做自然怀孕的这种情况,当然每一个患者最好能够考察一下自己自身是否会有这方面的原因,然后让医生给我们一个综合诊疗方案,其实这些诊疗方案相对来说都是特别适合患者的,我们可以结合自己的实际情况来进行诊疗。
-
如何解开备孕疑惑,轻松好孕?
备孕小夫妻,总是爱着急





